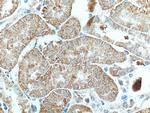
SAPS3 Antibody in Immunohistochemistry (Paraffin) (IHC (P))

Search
Proteintech
SAPS3 Polyclonal Antibody
{{$productOrderCtrl.translations['antibody.pdp.commerceCard.promotion.promotions']}}
{{$productOrderCtrl.translations['antibody.pdp.commerceCard.promotion.viewpromo']}}
{{$productOrderCtrl.translations['antibody.pdp.commerceCard.promotion.promocode']}}: {{promo.promoCode}} {{promo.promoTitle}} {{promo.promoDescription}}. {{$productOrderCtrl.translations['antibody.pdp.commerceCard.promotion.learnmore']}}
产品信息
16944-1-AP
种属反应
宿主/亚型
分类
类型
抗原
偶联物
形式
浓度
规格
纯化类型
保存液
内含物
保存条件
运输条件
产品详细信息
Immunogen sequence: VRERWETFC TSSLGETNKR NTVDLFGFND EKFADQDDIG NVSFDRVSDI NFTLNTNESG NIALFEACCK ERIQQFDDGG SDEEDIWEEK HIAFTPESQR RSSSGSTDSE ESTDSEEEDG AKQDLFEPSS ANTEDKMEVD LSEPPNWSAN FDVPMETTHG APLDSVGSDV WSTEEPMPTK ETGWASFSEF TSSLSTKDSL RSNSPVEMET STEPMDPLTP SAAALAVQPE AAGSVAMEAS SDGEEDAEST DKVTETVMNG GMKETLSLTV DAKTETAVFK SEEGKLSTSQ DAACKDAEEC PETAEAKCAA PRPPSSSPEQ RTGQPSAPGD TSVNGPV (1-336 aa encoded by BC020953)
靶标信息
RMI1 is an essential component of the RMI complex, a complex that plays an important role in the processing of homologous recombination intermediates to limit DNA crossover formation in cells. RMI1 promotes TOP3A binding to double Holliday junctions.
仅用于科研。不用于诊断过程。未经明确授权不得转售。
生物信息学
蛋白别名: DKFZp781E17107; DKFZp781E2374; DKFZp781O2362; FLJ11058; FLJ43065; isoform a; isoform b; MGC125711; MGC125712; pluripotent cell-specific 3; SAPS domain family member 3; SAPS domain family, member 3; SAPS domain family, member 3, pseudogene 1; Serine/threonine-protein phosphatase 6 regulatory subunit 3; sporulation-induced transcript 4-associated protein; Sporulation-induced transcript 4-associated protein SAPL; unnamed protein product
基因别名: 4930528G08Rik; 9130026N02Rik; C11orf23; D19Bwg1430e; D19Ertd703e; KIAA1558; mKIAA1558; PP6R3; Ppcs3; PPP6R3; Ppp6r3-ps1; Pptcs3; RGD1307145; SAP190; SAPL; SAPLa; SAPS3; Saps3-ps1
UniProt ID: (Human) Q5H9R7, (Mouse) Q922D4
Entrez Gene ID: (Human) 55291, (Mouse) 52036, (Rat) 309144